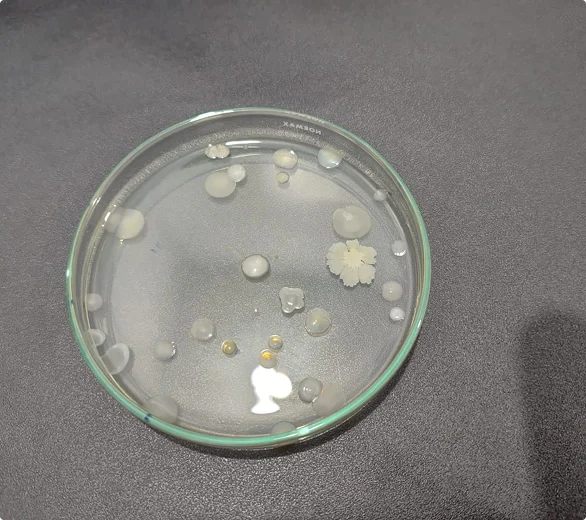
Qualin - Análises Ambientais

Serviços

Análise de Água
Realizamos a coleta de água em mananciais, poços, fontes, rios, lagos, represas, sistemas alternativos de abastecimento, reservatórios, nascentes, minas, Estações de Tratamento de Água (ETA), bebedouros, caixas de água, torneiras, saídas de filtros e máquinas de tratamento de água.
Os ensaios químicos e biológicos em água tratada, água para consumo humano e água bruta, garantem a qualidade dos corpos hídricos e o nível de potabilidade da água, de acordo com a legislação vigente.
Solicite um orçamento agora mesmo
Análise de Efluentes
Realizamos a coleta de água residual (efluentes) em Estações de tratamento, reservatórios, tanques fechados ou abertos, tanque enterrado, tambores, bombonas, tanques de decantação, caixas separadoras, lagoas, caminhões e caçambas, ETE's industriais e domésticas, redes coletoras de esgoto, redes de esgotamento sanitário, fossas, tanques sépticos, lagoas de tratamento (de resíduos sólidos e domésticos).
Os ensaios químicos e biológicos, realizados a montante e a jusante do despejo de efluentes, possibilita, a classificação e estudo conforme as normas e expectativas exigidas pelo CONAMA para descarte em corpos hídricos, definição dos melhores processos de tratamento e reúso de águas industriais.
Solicite um orçamento agora mesmo
Análises ambientais para área de saúde
Análises físico-químicas e microbiológicas em água purificada, água de hemodiálise, dialisato, oriundas de clínicas, hospitais, farmácias e estabelecimentos de saúde. Atendemos com base na Farmacopéia Brasileira, RDC e ANVISA dentre outras.
Solicite um orçamento agora mesmo
Análises ambientais para o agronegócio
Análises físico-químicas e microbiológicas em água de nascentes, reservatórios, lagos, lagoas, biodigestores, irrigação, água de processos artesanais, água de residências rurais, caixa de óleo de oficinas de máquinas agrícolas, piscicultura, Atendemos para Certificações Rain Forest, CONAMAs, Selo ABIC, dentre outras.
Solicite um orçamento agora mesmo
Análises de toxicidade e classificação em solos
Análises físico-químicas e microbiológicas em solos com objetivo de identificar toxicidade e fazer classificação nas ABNT 10004, 10005, 10006 e 10007
Solicite um orçamento agora mesmo
Análises ambientais para controle de alimentos
Análises físico-químicas e microbiológicas em água de processos alimentícios, água mineral, condições ambientais de bancadas e utensílios, Atendemos IN 161, RDC 717 dentre outras pertinentes.
Solicite um orçamento agora mesmo